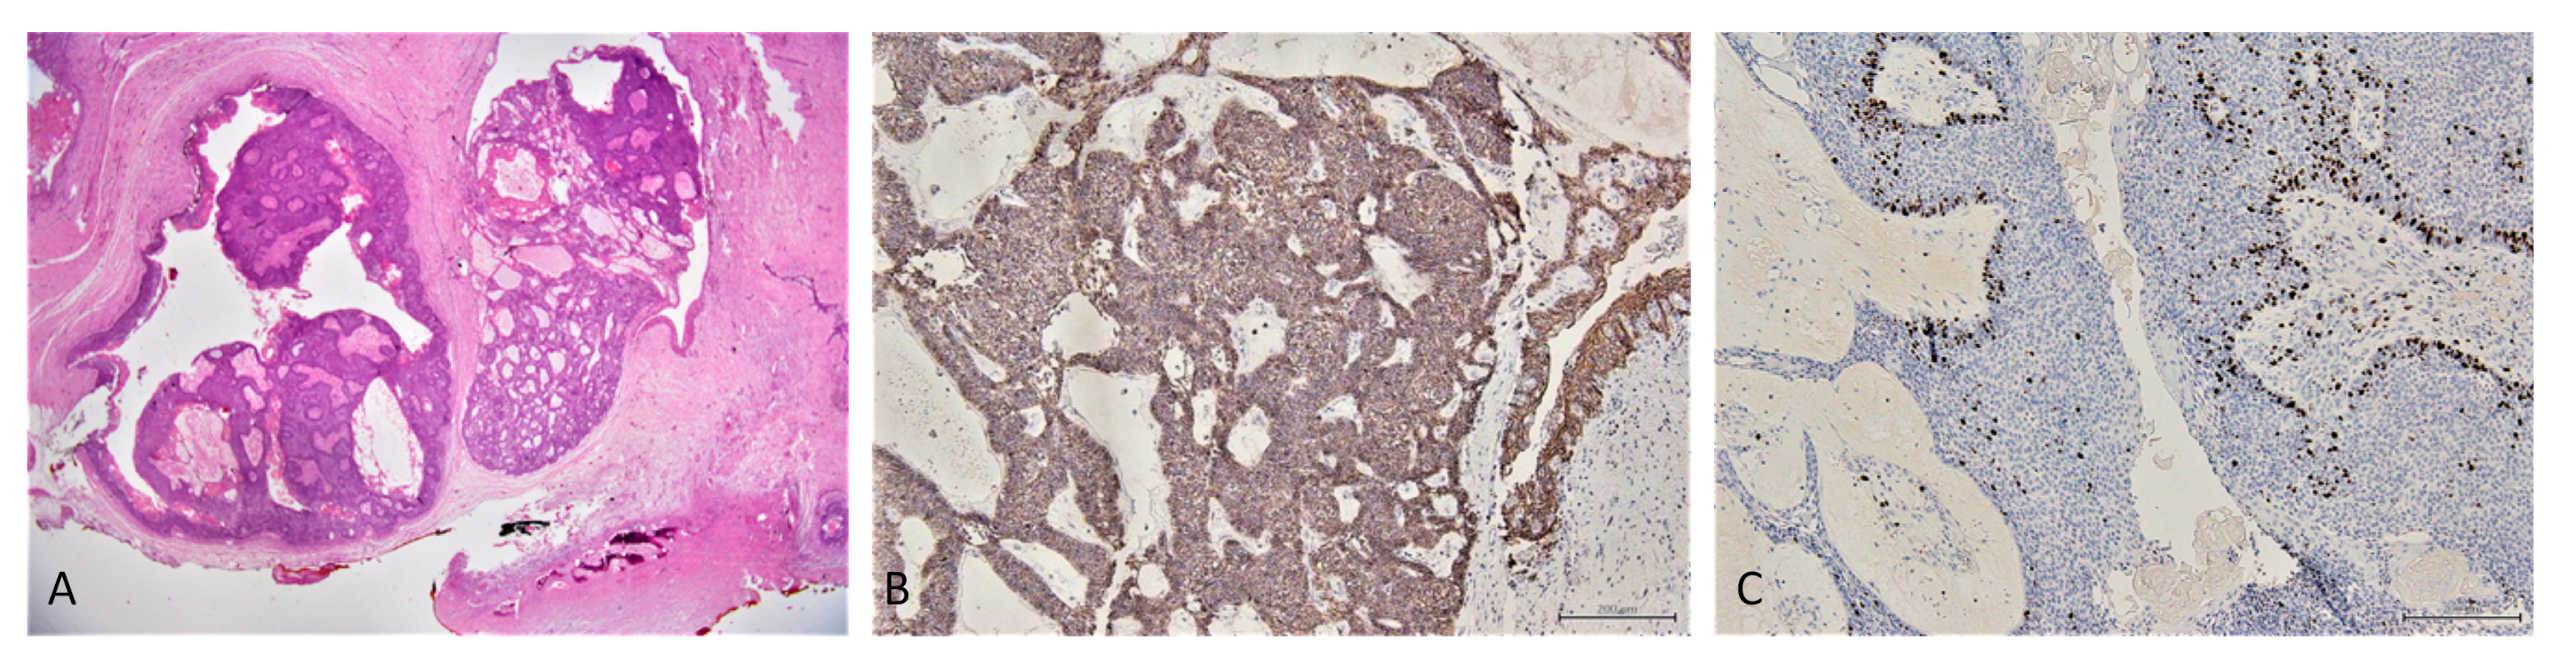
Reports 05 00010 g007

Ameloblastoma in a Three-Year-Old Child with Hurler Syndrome (Mucopolysaccharidosis Type I)
Abstract
:1. Introduction
- Hurler syndrome (HS): severe phenotype;
- Hurler–Scheie syndrome (H–SS): intermediate phenotype;
- Scheie syndrome (SS): mild phenotype [2].
2. Case Presentation
2.1. Clinical and Preoperative Radiological Presentation
2.2. Incisional Biopsy Findings
2.3. Surgical Management
2.4. Conventional Ameloblastoma Diagnosis

2.5. Follow-Up
3. Discussion
4. Conclusions
Author Contributions
Funding
Institutional Review Board Statement
Informed Consent Statement
Data Availability Statement
Acknowledgments
Conflicts of Interest
References
- Sawamoto, K.; Chen, H.-H.; Alméciga-Díaz, C.J.; Mason, R.W.; Tomatsu, S. Gene therapy for Mucopolysaccharidoses. Mol. Genet. Metab. 2018, 123, 59–68. [Google Scholar] [CrossRef] [PubMed]
- Hampe, C.S.; Eisengart, J.B.; Lund, T.C.; Orchard, P.J.; Swietlicka, M.; Wesley, J.; McIvor, R.S. Mucopolysaccharidosis Type I: A Review of the Natural History and Molecular Pathology. Cells 2020, 9, 1838. [Google Scholar] [CrossRef] [PubMed]
- Khan, S.A.; Peracha, H.; Ballhausen, D.; Wiesbauer, A.; Rohrbach, M.; Gautschi, M.; Mason, R.W.; Giugliani, R.; Suzuki, Y.; Orii, K.E.; et al. Epidemiology of mucopolysaccharidoses. Mol. Genet. Metab. 2017, 121, 227–240. [Google Scholar] [CrossRef] [PubMed]
- Poorthuis, B.J.; Wevers, R.A.; Kleijer, W.J.; Groener, J.E.; de Jong, J.G.; van Weely, S.; Niezen-Koning, K.E.; van Diggelen, O.P. The frequency of lysosomal storage diseases in The Netherlands. Hum. Genet. 1999, 105, 151–156. [Google Scholar] [CrossRef]
- Malm, G.; Lund, A.M.; Månsson, J.-E.; Heiberg, A. Mucopolysaccharidoses in the Scandinavian countries: Incidence and prevalence. Acta Paediatr. 2008, 97, 1577–1581. [Google Scholar] [CrossRef]
- Hobbs, J.R.; Hugh-Jones, K.; Barrett, A.J.; Byrom, N.; Chambers, D.; Henry, K.; James, D.C.; Lucas, C.F.; Rogers, T.R.; Benson, P.F.; et al. Reversal of clinical features of Hurler’s disease and biochemical improvement after treatment by bone-marrow transplantation. Lancet 1981, 2, 709–712. [Google Scholar] [CrossRef]
- Gardner, D.G. The oral manifestations of Hurler’s syndrome. Oral Surg. Oral Med. Oral Pathol. 1971, 32, 46–57. [Google Scholar] [CrossRef]
- Simonaro, C.M.; D’Angelo, M.; He, X.; Eliyahu, E.; Shtraizent, N.; Haskins, M.E.; Schuchman, E.H. Mechanism of glycosaminoglycan-mediated bone and joint disease: Implications for the mucopolysaccharidoses and other connective tissue diseases. Am. J. Pathol. 2008, 172, 112–122. [Google Scholar] [CrossRef] [Green Version]
- Worth, H.M. Hurler’s syndrome. A study of radiologic appearances in the jaws. Oral Surg. Oral Med. Oral Pathol. 1966, 22, 21–35. [Google Scholar] [CrossRef]
- Hingston, E.J.; Hunter, M.L.; Hunter, B.; Drage, N. Hurler’s syndrome: Dental findings in a case treated with bone marrow transplantation in infancy. Int. J. Paediatr. Dent. 2006, 16, 207–212. [Google Scholar] [CrossRef]
- McGovern, E.; Owens, L.; Nunn, J.; Bolas, A.; Meara, A.O.; Fleming, P. Oral features and dental health in Hurler Syndrome following hematopoietic stem cell transplantation. Int. J. Paediatr. Dent. 2010, 20, 322–329. [Google Scholar] [CrossRef]
- Guven, G.; Cehreli, Z.C.; Altun, C.; Sençimen, M.; Ide, S.; Bayari, S.H.; Karaçay, S. Mucopolysaccharidosis type I (Hurler syndrome): Oral and radiographic findings and ultrastructural/chemical features of enamel and dentin. Oral Surg. Oral Med. Oral Pathol. Oral Radiol. Endod. 2008, 105, 72–78. [Google Scholar] [CrossRef]
- Gomes, C.C.; Duarte, A.P.; Diniz, M.G.; Gomez, R.S. Review article: Current concepts of ameloblastoma pathogenesis. J. Oral Pathol. Med. 2010, 39, 585–591. [Google Scholar] [CrossRef]
- Okechi, U.C.; Akpeh, J.O.; Chukwuneke, F.N.; Saheeb, B.D.; Okwuosa, C.U.; Obi, D.I.; Ogbozor, B.E. Ameloblastoma of the jaws in children: An evaluation of cases seen in a tertiary hospital in South-Eastern Nigeria. Ghana Med. J. 2020, 54, 36–41. [Google Scholar] [CrossRef]
- Regezi, J.A.; Kerr, D.A.; Courtney, R.M. Odontogenic tumors: Analysis of 706 cases. J. Oral Surg. 1978, 36, 771–778. [Google Scholar]
- McClary, A.C.; West, R.B.; McClary, A.C.; Pollack, J.R.; Fischbein, N.J.; Holsinger, C.F.; Sunwoo, J.; Colevas, A.D.; Sirjani, D. Ameloblastoma: A clinical review and trends in management. Eur. Arch. Otorhinolaryngol. 2016, 273, 1649–1661. [Google Scholar] [CrossRef]
- Wright, J.M.; Vered, M. Update from the 4th Edition of the World Health Organization Classification of Head and Neck Tumours: Odontogenic and Maxillofacial Bone Tumors. Head Neck Pathol. 2017, 11, 68–77. [Google Scholar] [CrossRef] [Green Version]
- El-Naggar, A.K.; Chan, J.K.C.; Rubin Grandis, J.; Takata, T.; Slootweg, P.J. International Agency for Research on Cancer WHO Classification of Head and Neck Tumours, 4th ed.; IARC: Lyon, France, 2017; ISBN 9789283224389. [Google Scholar]
- Negrello, S.; Pellacani, A.; di Bartolomeo, M.; Bernardelli, G.; Nocini, R.; Pinelli, M.; Chiarini, L.; Anesi, A. Primary Intraosseous Squamous Cell Carcinoma of the Anterior Mandible Arising in an Odontogenic Cyst in 34-Year-Old Male. Rep. Med. Cases Images Videos 2020, 3, 12. [Google Scholar] [CrossRef]
- Soluk-Tekkeşin, M.; Wright, J.M. The World Health Organization Classification of Odontogenic Lesions: A Summary of the Changes of the 2017 (4th) Edition. Turk Patoloji Derg. 2018, 34, 1–18. [Google Scholar] [CrossRef]
- Bilodeau, E.A.; Hunter, K.D. Odontogenic and Developmental Oral Lesions in Pediatric Patients. Head Neck Pathol. 2021, 15, 71–84. [Google Scholar] [CrossRef]
- Abrahams, J.M.; McClure, S.A. Pediatric Odontogenic Tumors. Oral Maxillofac. Surg. Clin. N. Am. 2016, 28, 45–58. [Google Scholar] [CrossRef]
- Perry, K.S.; Tkaczuk, A.T.; Caccamese, J.F.; Ord, R.A.; Pereira, K.D. Tumors of the pediatric maxillofacial skeleton: A 20-year clinical study. JAMA Otolaryngol. Head Neck Surg. 2015, 141, 40–44. [Google Scholar] [CrossRef] [PubMed] [Green Version]
- Ard, J.L.; Bekker, A.; Frempong-Boadu, A.K. Anesthesia for an adult with mucopolysaccharidosis I. J. Clin. Anesth. 2005, 17, 624–626. [Google Scholar] [CrossRef] [PubMed]
- Clark, B.M.; Sprung, J.; Weingarten, T.N.; Warner, M.E. Anesthesia for patients with mucopolysaccharidoses: Comprehensive review of the literature with emphasis on airway management. Bosn. J. Basic Med. Sci. 2018, 18, 1–7. [Google Scholar] [CrossRef] [PubMed] [Green Version]
- Kirkpatrick, K.; Ellwood, J.; Walker, R.W.M. Mucopolysaccharidosis type I (Hurler syndrome) and anesthesia: The impact of bone marrow transplantation, enzyme replacement therapy, and fiberoptic intubation on airway management. Paediatr. Anaesth. 2012, 22, 745–751. [Google Scholar] [CrossRef] [PubMed]
- Ganzberg, S. The FDA Warning on Anesthesia Drugs. Anesth. Prog. 2017, 64, 57–58. [Google Scholar] [CrossRef] [Green Version]
- Cavuoto, K.M.; Rodriguez, L.I.; Tutiven, J.; Chang, T.C. General anesthesia in the pediatric population. Curr. Opin. Ophthalmol. 2014, 25, 411–416. [Google Scholar] [CrossRef]
- Liu, Z.; Liu, J.; Zhou, Z.; Zhang, Q.; Wu, H.; Zhai, G.; Han, J. Differential diagnosis of ameloblastoma and odontogenic keratocyst by machine learning of panoramic radiographs. Int. J. Comput. Assist. Radiol. Surg. 2021, 16, 415–422. [Google Scholar] [CrossRef]
- Cipriano, M.; Allegretti, S.; Bolelli, F.; Di Bartolomeo, M.; Pollastri, F.; Pellacani, A.; Minafra, P.; Anesi, A.; Grana, C. Deep Segmentation of the Mandibular Canal: A New 3D Annotated Dataset of CBCT Volumes. IEEE Access 2022, 10, 11500–11510. [Google Scholar] [CrossRef]
- Di Bartolomeo, M.; Pellacani, A.; Negrello, S.; Chiarini, L.; Anesi, A. Emerging challenges and possible strategies in maxillo-facial and oral surgery during the COVID-19 pandemic. J. Oral Sci. 2020, 62, 452–454. [Google Scholar] [CrossRef]
- Thakur, A.R.; Naikmasur, V.G.; Sattur, A. Hurler syndrome: Orofacial, dental, and skeletal findings of a case. Skeletal Radiol. 2015, 44, 579–586. [Google Scholar] [CrossRef]
- Mercadante, C.; Cipriano, M.; Bolelli, F.; Pollastri, F.; Di Bartolomeo, M.; Anesi, A.; Grana, C. A Cone Beam Computed Tomography Annotation Tool for Automatic Detection of the Inferior Alveolar Nerve Canal. In Proceedings of the 16th International Joint Conference on Computer Vision, Imaging and Computer Graphics Theory and Applications, Vienna, Austria, 8–10 February 2021; SCITEPRESS—Science and Technology Publications: Setubal, Portugal, 2021; Volume 4, pp. 724–731. [Google Scholar]
- Yang, R.; Tang, Y.; Zhang, X.; Liu, Z.; Gokavarapu, S.; Lin, C.; Ren, Z.; Zhou, Y.; Cao, W.; Ji, T. Recurrence factors in pediatric ameloblastoma: Clinical features and a new classification system. Head Neck 2019, 41, 3491–3498. [Google Scholar] [CrossRef]
- Mendenhall, W.M.; Werning, J.W.; Fernandes, R.; Malyapa, R.S.; Mendenhall, N.P. Ameloblastoma. Am. J. Clin. Oncol. 2007, 30, 645–648. [Google Scholar] [CrossRef]
- Dorosz, N.; Dominiak, M. Mandibular ridge reconstruction: A review of contemporary methods. Adv. Clin. Exp. Med. 2018, 27, 1159–1168. [Google Scholar] [CrossRef]
- Anesi, A.; Di Bartolomeo, M.; Pellacani, A.; Ferretti, M.; Cavani, F.; Salvatori, R.; Nocini, R.; Palumbo, C.; Chiarini, L. Bone Healing Evaluation Following Different Osteotomic Techniques in Animal Models: A Suitable Method for Clinical Insights. Appl. Sci. 2020, 10, 7165. [Google Scholar] [CrossRef]
- Clarke, L.A.; Giugliani, R.; Guffon, N.; Jones, S.A.; Keenan, H.A.; Munoz-Rojas, M.V.; Okuyama, T.; Viskochil, D.; Whitley, C.B.; Wijburg, F.A.; et al. Genotype-phenotype relationships in mucopolysaccharidosis type I (MPS I): Insights from the International MPS I Registry. Clin. Genet. 2019, 96, 281–289. [Google Scholar] [CrossRef] [Green Version]
- Hunter, K.D.; Speight, P.M. The diagnostic usefulness of immunohistochemistry for odontogenic lesions. Head Neck Pathol. 2014, 8, 392–399. [Google Scholar] [CrossRef] [Green Version]
- Sherlin, H.J.; Natesan, A.; Ram, P.; Ramani, P.; Thiruvenkadam, C. Immunohistochemical profiling of Ameloblastomas using cytokeratin, vimentin, smooth muscle actin, CD34 and S100. Ann. Maxillofac. Surg. 2013, 3, 51–57. [Google Scholar] [CrossRef] [Green Version]
- Kelppe, J.; Thorén, H.; Haglund, C.; Sorsa, T.; Hagström, J. MMP-7, -8, -9, E-cadherin, and beta-catenin expression in 34 ameloblastoma cases. Clin. Exp. Dent. Res. 2021, 7, 63–69. [Google Scholar] [CrossRef]
- Effiom, O.A.; Ogundana, O.M.; Akinshipo, A.O.; Akintoye, S.O. Ameloblastoma: Current etiopathological concepts and management. Oral Dis. 2018, 24, 307–316. [Google Scholar] [CrossRef] [Green Version]
- Shi, H.A.; Ng, C.W.B.; Kwa, C.T.; Sim, Q.X.C. Ameloblastoma: A succinct review of the classification, genetic understanding and novel molecular targeted therapies. Surgeon 2021, 19, 238–243. [Google Scholar] [CrossRef] [PubMed]
- Kurppa, K.J.; Catón, J.; Morgan, P.R.; Ristimäki, A.; Ruhin, B.; Kellokoski, J.; Elenius, K.; Heikinheimo, K. High frequency of BRAF V600E mutations in ameloblastoma. J. Pathol. 2014, 232, 492–498. [Google Scholar] [CrossRef] [PubMed] [Green Version]
- Hirschhorn, A.; Campino, G.A.; Vered, M.; Greenberg, G.; Yacobi, R.; Yahalom, R.; Barshack, I.; Toren, A.; Amariglio, N.; Rechavi, G. Upfront rational therapy in BRAF V600E mutated pediatric ameloblastoma promotes ad integrum mandibular regeneration. J. Tissue Eng. Regen. Med. 2021, 15, 1155–1161. [Google Scholar] [CrossRef] [PubMed]

| General Features | Present Case |
|---|---|
| Psychomotor impairment | Fulfilled |
| Eye disorders | Unfulfilled |
| Cardiomyopathy | Fulfilled |
| Aortic and mitral valve disease | Fulfilled |
| Hepatosplenomegaly | Unfulfilled |
| Musculoskeletal features | |
| Disproportionate short stature | Unfulfilled |
| Joint contractures | Unfulfilled |
| Carpal tunnel syndrome (CTS) | Unfulfilled |
| Atlanto-axial instability | Unfulfilled |
| Acetabular dysplasia | Fulfilled |
| Coxa valga | Fulfilled |
| Genu valgum | Unfulfilled |
| Trigger digits | Unfulfilled |
| Cranio-facial characteristics | |
| Coarse facies | Fulfilled |
| Gum hypertrophy | Unfulfilled |
| Macroglossia | Unfulfilled |
| Dysostosis multiplex | Fulfilled |
| Odontoid hypoplasia | Fulfilled |
Publisher’s Note: MDPI stays neutral with regard to jurisdictional claims in published maps and institutional affiliations. |
© 2022 by the authors. Licensee MDPI, Basel, Switzerland. This article is an open access article distributed under the terms and conditions of the Creative Commons Attribution (CC BY) license (https://creativecommons.org/licenses/by/4.0/).
Share and Cite
Di Bartolomeo, M.; Pellacani, A.; Negrello, S.; Buchignani, M.; Nocini, R.; Di Massa, G.; Gianotti, G.; Pollastri, G.; Colletti, G.; Chiarini, L.; et al. Ameloblastoma in a Three-Year-Old Child with Hurler Syndrome (Mucopolysaccharidosis Type I). Reports 2022, 5, 10. https://doi.org/10.3390/reports5010010
Di Bartolomeo M, Pellacani A, Negrello S, Buchignani M, Nocini R, Di Massa G, Gianotti G, Pollastri G, Colletti G, Chiarini L, et al. Ameloblastoma in a Three-Year-Old Child with Hurler Syndrome (Mucopolysaccharidosis Type I). Reports. 2022; 5(1):10. https://doi.org/10.3390/reports5010010
Chicago/Turabian StyleDi Bartolomeo, Mattia, Arrigo Pellacani, Sara Negrello, Martina Buchignani, Riccardo Nocini, Gianluca Di Massa, Greta Gianotti, Giuseppe Pollastri, Giacomo Colletti, Luigi Chiarini, and et al. 2022. "Ameloblastoma in a Three-Year-Old Child with Hurler Syndrome (Mucopolysaccharidosis Type I)" Reports 5, no. 1: 10. https://doi.org/10.3390/reports5010010
APA StyleDi Bartolomeo, M., Pellacani, A., Negrello, S., Buchignani, M., Nocini, R., Di Massa, G., Gianotti, G., Pollastri, G., Colletti, G., Chiarini, L., & Anesi, A. (2022). Ameloblastoma in a Three-Year-Old Child with Hurler Syndrome (Mucopolysaccharidosis Type I). Reports, 5(1), 10. https://doi.org/10.3390/reports5010010

